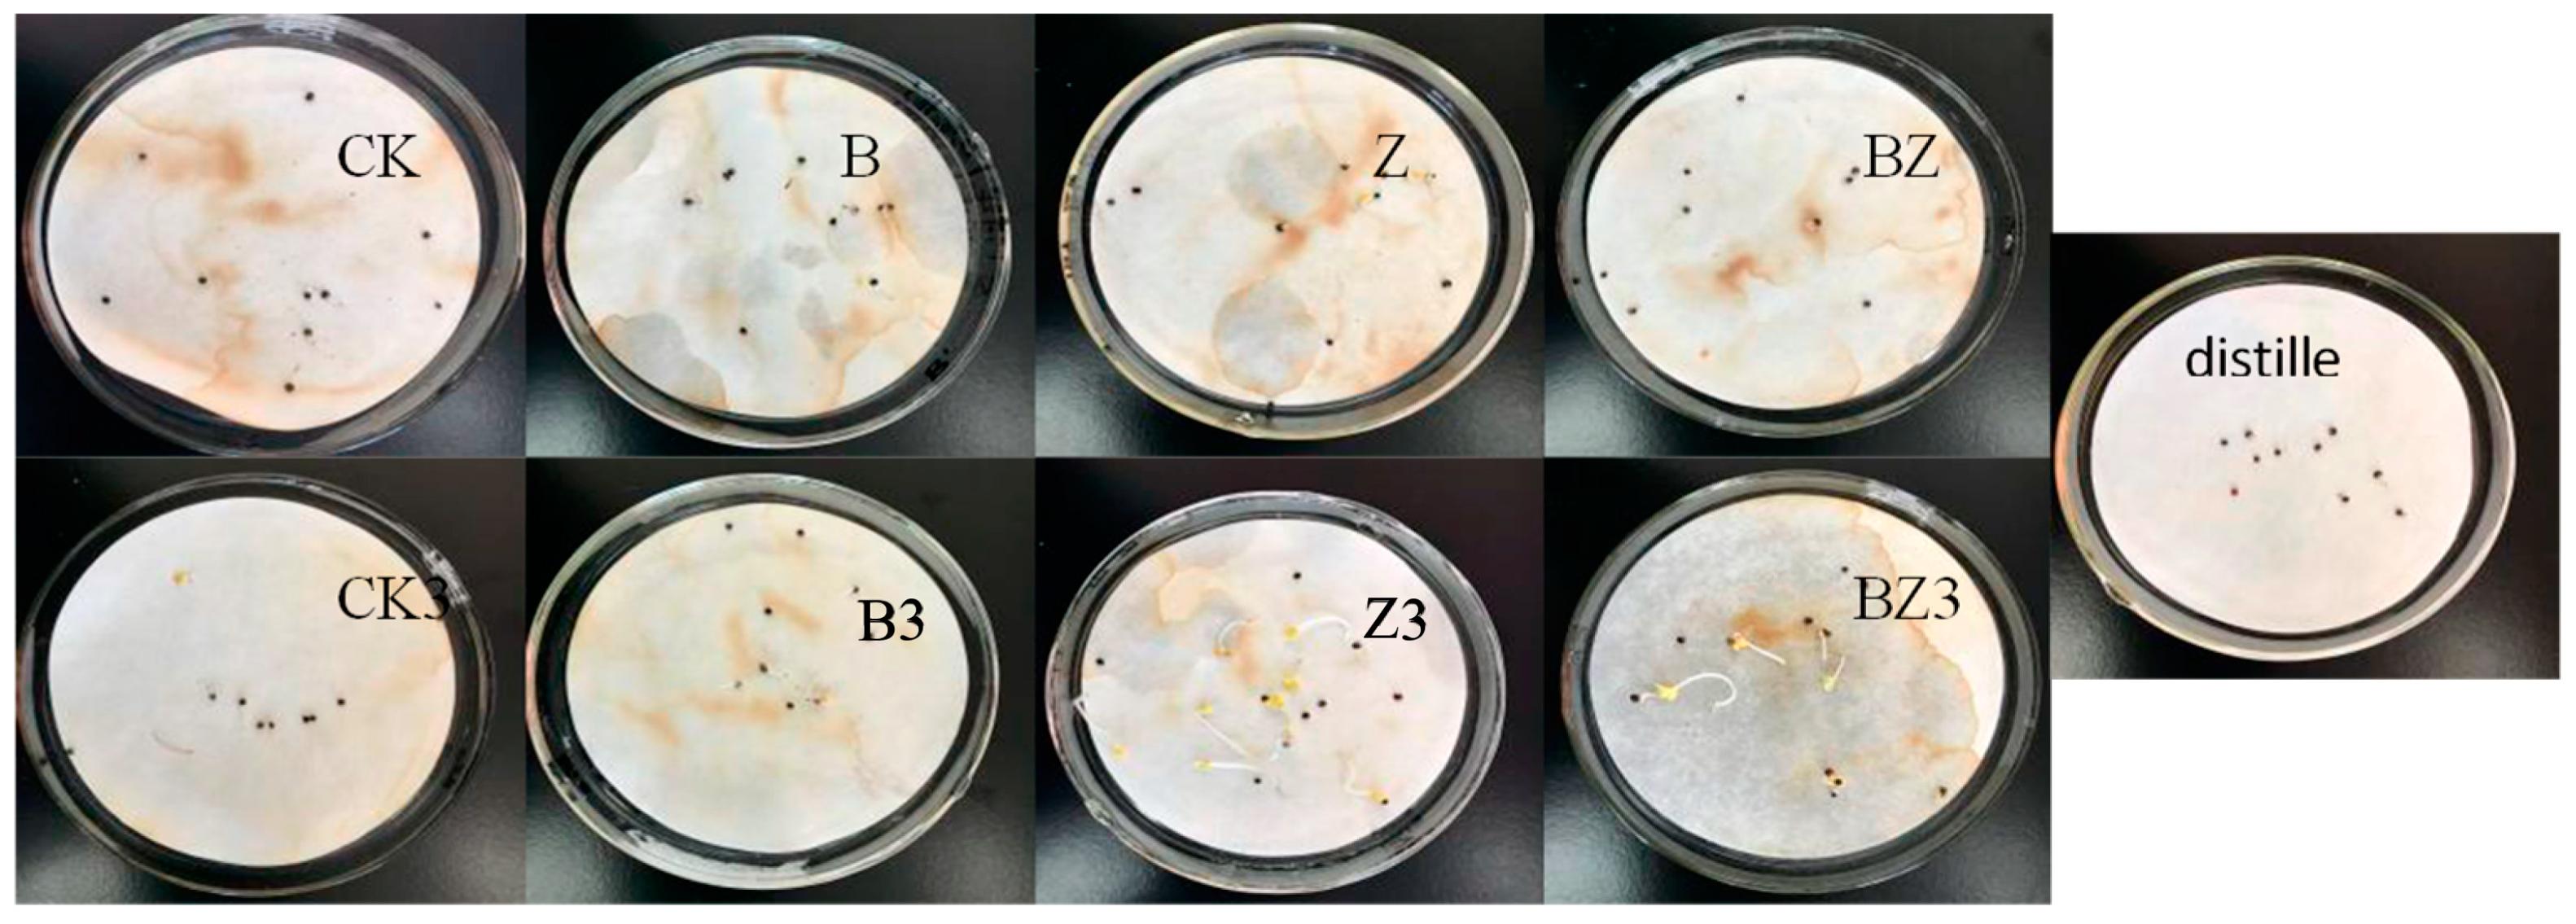

Study of the Relationship Between Nitrogen, Phosphorus Content, and Microbial Community Changes in Deer Manure Compost with Different Conditioners
Abstract
1. Introduction
2. Materials and Methods
2.1. Compost Materials and Properties
2.2. Experimental Design
2.2.1. The Impact of Conditioners on the Aerobic Composting Process of Deer Manure
2.2.2. The Impact of Conditioner on the Phytotoxicity and Decomposition of Deer Manure Compost
2.3. Methods for Determining Physicochemical Indicators
2.4. Analysis of Microbial Community Structure
2.5. Statistical Analysis
3. Results
3.1. Variations in Carbon, Nitrogen, and Phosphorus Levels in Reactor Under Distinct Conditioning Agents
3.2. The Impact of Various Conditioners on Microbial Community Alterations in Reactors
3.3. The Impact of Conditioners on the Phytotoxicity and Maturation Process of Deer Manure Compost
4. Conclusions
- (1)
- The conditioner significantly enhanced the degradation of organic matter, with the following order of effectiveness: BZ (34.83%) > Z (26.52%) > B (22.12%). The inclusion of biochar helped to mitigate nitrogen loss in the compost heap, with the peak TN content of composting reaching 39.55 g/kg. Additionally, the incorporation of zeolite and biochar modified is beneficial for the retention of phosphorus in the reactor, with the zeolite demonstrating a positive effect, resulting in a phosphorus content of 47.47 g/kg in the reactor.
- (2)
- Dominant strains during the compost cooling phase differed markedly from those prevalent in the warming and high-temperature phases. During the warming and high-temperature stages, the dominant species were bacteria such as Psychrobacter, Tuicibacter, and Glutamicibacter, along with fungi like Botryotrichum, Aspergillus, and Mucor. In contrast, the cooling phase saw a shift to bacterial species including Luteimonas, Pseudomonas, Chryseolinea, and fungal species Mycothermus and Thermomyces.
- (3)
- The redundant analysis revealed that using biochar and zeolite as conditioners altered the bacterial community structure. Environmental factors influenced this change in microbial community structure; TN (p = 0.002), C/N (p = 0.004), TP (p = 0.006), and TOC (p = 0.008) had significant impacts on the bacterial community structure, accounting for 66.1%, 62.6%, 56.0%, and 49.4%, respectively. Notably, changes in Coryneba, Acinetob, and Glutamic were positively associated with alterations in the C/N ratio and negatively correlated with TN and TP.
- (4)
- Composting effectively mitigated the phytotoxicity inherent in deer manure. The incorporation of compost products, when combined with biochar and zeolite conditioners, exhibited minimal toxicity, resulting in a negligible impact on seed germination, as evidenced by a GI value of 98.5%. Notably, the addition of a conditioner comprising a mixture of biochar and zeolite yielded the highest degree of composting decay. This mixture demonstrated the strongest correlation with the maturation process, evidenced by a correlation coefficient of 0.8346.
Author Contributions
Funding
Institutional Review Board Statement
Informed Consent Statement
Data Availability Statement
Conflicts of Interest
References
- Ran, H.; Li, J. The current status and development of agricultural waste resourceization and the use of rural biomass energy use. Energy Conserv. Environ. Prot. 2019, 6, 75–76. [Google Scholar]
- Shi, K.; Xue, J.; Hu, S. Treatment and utilization of agricultural solid waste. World Environ. 2018, 5, 19–22. [Google Scholar]
- Wang, H.; Yao, D.; Xu, J.; Liu, X.; Sheng, L. Investigation of Technology for Composting Mixed Deer Manure and Straw. Environ. Sci. Pollut. Res. 2021, 28, 45805–45825. [Google Scholar] [CrossRef]
- Wang, H.; Lu, Y.; Xu, J.; Liu, X.; Sheng, L. Effects of Additives on Nitrogen Transformation and Greenhouse Gases Emission of Co-Composting for Deer Manure and Corn Straw. Environ. Sci. Pollut. Res. 2021, 28, 13000–13020. [Google Scholar] [CrossRef] [PubMed]
- Shuangyang District People’s Government of Changchun City. Available online: http://www.shuangyang.gov.cn/zjsy/tssy/sygk/ (accessed on 17 November 2024).
- Adesokan, H.K.; Ocheja, S.E. Knowledge, Attitudes and Practices of Traceability among Livestock Traders in South-Western Nigeria: Implications for Sustainable Livestock Industry. Trop. Anim. Health. Prod. 2014, 46, 159–165. [Google Scholar] [CrossRef] [PubMed]
- Wang, H.; Xu, J.; Liu, X.; Sheng, L.; Zhang, D.; Li, L.; Wang, A. Study on the Pollution Status and Control Measures for the Livestock and Poultry Breeding Industry in Northeastern China. Environ. Sci. Pollut. Res. 2018, 25, 4435–4445. [Google Scholar] [CrossRef] [PubMed]
- Wang, H.; Xu, J.; Sheng, L. Study on the Comprehensive Utilization of City Kitchen Waste as a Resource in China. Energy 2019, 173, 263–277. [Google Scholar] [CrossRef]
- Cao, Z.; Qin, X.; Wen, X.; Sun, R.; Fu, M.; Li, Q. Modified Illite/Smectite Clay Promoted Composting Humification and Maturation Mediated by Reducing Greenhouse Gas Emissions. Biomass Conv. Bioref. 2024, 14, 1–13. [Google Scholar] [CrossRef]
- Xu, Z.; Li, R.; KuoK Ho Tang, D.; Zhang, X.; Zhang, X.; Liu, H.; Quan, F. Enhancing Nitrogen Transformation and Humification in Cow Manure Composting through Psychrophilic and Thermophilic Nitrifying Bacterial Consortium Inoculation. Bioresour. Technol. 2024, 413, 131507. [Google Scholar] [CrossRef]
- Ye, P.; Fang, L.; Song, D.; Zhang, M.; Li, R.; Awasthi, M.K.; Zhang, Z.; Xiao, R.; Chen, X. Insights into Carbon Loss Reduction during Aerobic Composting of Organic Solid Waste: A Meta-Analysis and Comprehensive Literature Review. Sci. Total Environ. 2023, 862, 160787. [Google Scholar] [CrossRef] [PubMed]
- Yan, H.; Yang, H.; Li, K.; Zhu, P.; Li, X.; Li, Q. Biochar Addition Modified Carbon Flux and Related Microbiota in Cow Manure Composting. Waste Biomass Valor. 2023, 14, 847–858. [Google Scholar] [CrossRef]
- Gu, B.; Zhang, X.; Lam, S.K.; Yu, Y.; van Grinsven, H.J.M.; Zhang, S.; Wang, X.; Bodirsky, B.L.; Wang, S.; Duan, J.; et al. Cost-Effective Mitigation of Nitrogen Pollution from Global Croplands. Nature 2023, 613, 77–84. [Google Scholar] [CrossRef]
- Zhang, C.; Zeng, G.; Huang, D.; Lai, C.; Chen, M.; Cheng, M.; Tang, W.; Tang, L.; Dong, H.; Huang, B.; et al. Biochar for Environmental Management: Mitigating Greenhouse Gas Emissions, Contaminant Treatment, and Potential Negative Impacts. Chem. Eng. J. 2019, 373, 902–922. [Google Scholar] [CrossRef]
- López-Cano, I.; Roig, A.; Cayuela, M.L.; Alburquerque, J.A.; Sánchez-Monedero, M.A. Biochar Improves N Cycling during Composting of Olive Mill Wastes and Sheep Manure. Waste Manag. 2016, 49, 553–559. [Google Scholar] [CrossRef] [PubMed]
- Das, S.K.; Ghosh, G.K.; Avasthe, R. Biochar Application for Environmental Management and Toxic Pollutant Remediation. Biomass Conv. Bioref. 2023, 13, 555–566. [Google Scholar] [CrossRef]
- Sanchez-Monedero, M.A.; Cayuela, M.L.; Roig, A.; Jindo, K.; Mondini, C.; Bolan, N. Role of Biochar as an Additive in Organic Waste Composting. Bioresour. Technol. 2018, 247, 1155–1164. [Google Scholar] [CrossRef] [PubMed]
- Wei, L.; Shutao, W.; Jin, Z.; Tong, X. Biochar Influences the Microbial Community Structure during Tomato Stalk Composting with Chicken Manure. Bioresour. Technol. 2014, 154, 148–154. [Google Scholar] [CrossRef] [PubMed]
- Qu, C.; Chen, W.; Hu, X.; Cai, P.; Chen, C.; Yu, X.-Y.; Huang, Q. Heavy Metal Behaviour at Mineral-Organo Interfaces: Mechanisms, Modelling and Influence Factors. Environ. Int. 2019, 131, 104995. [Google Scholar] [CrossRef] [PubMed]
- Zhang, L.; Sun, X. Effects of Earthworm Casts and Zeolite on the Two-Stage Composting of Green Waste. Waste Manag. 2015, 39, 119–129. [Google Scholar] [CrossRef] [PubMed]
- Duan, M.; Zhang, Y.; Zhou, B.; Wang, Q.; Gu, J.; Liu, G.; Qin, Z.; Li, Z. Changes in Antibiotic Resistance Genes and Mobile Genetic Elements during Cattle Manure Composting after Inoculation with Bacillus Subtilis. Bioresour. Technol. 2019, 292, 122011. [Google Scholar] [CrossRef] [PubMed]
- Wang, X.; Feng, J.; Haider, M.A.; Xu, J.; Sun, J.; Chen, Y. Study on the Effect of Conditioners on the Degradation of Tetracycline Antibiotics in Deer Manure Composting. Fermentation 2024, 10, 575. [Google Scholar] [CrossRef]
- Wang, Q.; Awasthi, M.K.; Ren, X.; Zhao, J.; Li, R.; Wang, Z.; Chen, H.; Wang, M.; Zhang, Z. RETRACTED: Comparison of Biochar, Zeolite and Their Mixture Amendment for Aiding Organic Matter Transformation and Nitrogen Conservation during Pig Manure Composting. Bioresour. Technol. 2017, 245, 300–308. [Google Scholar] [CrossRef]
- Wang, H.; Xu, J.; Sheng, L.; Teng, H. Study on Treatment of City Tail Water by Constructed Wetland with Corn Straw Biochar Substrate. Environ. Technol. Innov. 2022, 28, 102855. [Google Scholar] [CrossRef]
- NY525-2021; Organic Fertilizer. China Agricultural Press: Beijing, China, 2021.
- HJ 634-2012; Soil-Determination of Ammonium, Nitrite and Nitrate by Extraction with Potassium Chloride Solution -Spectrophotometric Methods. China Agricultural Press: Beijing, China, 2012.
- Norman, R.J.; Edberg, J.C.; Stucki, J.W. Determination of Nitrate in Soil Extracts by Dual-wavelength Ultraviolet Spectrophotometry. Soil Sci. Soc. Am. J. 1985, 49, 1182–1185. [Google Scholar] [CrossRef]
- Dias, B.O.; Silva, C.A.; Higashikawa, F.S.; Roig, A.; Sánchez-Monedero, M.A. Use of Biochar as Bulking Agent for the Composting of Poultry Manure: Effect on Organic Matter Degradation and Humification. Bioresour. Technol. 2010, 101, 1239–1246. [Google Scholar] [CrossRef] [PubMed]
- Chen, W.; Liao, X.; Wu, Y.; Liang, J.B.; Mi, J.; Huang, J.; Zhang, H.; Wu, Y.; Qiao, Z.; Li, X.; et al. Effects of Different Types of Biochar on Methane and Ammonia Mitigation during Layer Manure Composting. Waste Manag. 2017, 61, 506–515. [Google Scholar] [CrossRef] [PubMed]
- Janczak, D.; Malińska, K.; Czekała, W.; Cáceres, R.; Lewicki, A.; Dach, J. Biochar to Reduce Ammonia Emissions in Gaseous and Liquid Phase during Composting of Poultry Manure with Wheat Straw. Waste Manag. 2017, 66, 36–45. [Google Scholar] [CrossRef]
- Agyarko-Mintah, E.; Cowie, A.; Van Zwieten, L.; Singh, B.P.; Smillie, R.; Harden, S.; Fornasier, F. Biochar Lowers Ammonia Emission and Improves Nitrogen Retention in Poultry Litter Composting. Waste Manag. 2017, 61, 129–137. [Google Scholar] [CrossRef]
- Agyarko-Mintah, E.; Cowie, A.; Singh, B.P.; Joseph, S.; Van Zwieten, L.; Cowie, A.; Harden, S.; Smillie, R. Biochar Increases Nitrogen Retention and Lowers Greenhouse Gas Emissions When Added to Composting Poultry Litter. Waste Manag. 2017, 61, 138–149. [Google Scholar] [CrossRef]
- Garcia-Rodríguez, A.; Matamoros, V.; Fontàs, C.; Salvadó, V. The Influence of Light Exposure, Water Quality and Vegetation on the Removal of Sulfonamides and Tetracyclines: A Laboratory-Scale Study. Chemosphere 2013, 90, 2297–2302. [Google Scholar] [CrossRef]
- Liu, N.; Zhou, J.; Han, L.; Ma, S.; Sun, X.; Huang, G. Role and Multi-Scale Characterization of Bamboo Biochar during Poultry Manure Aerobic Composting. Bioresour. Technol. 2017, 241, 190–199. [Google Scholar] [CrossRef] [PubMed]
- Yun, P.; Ma, Q.; Huang, M.; Yan, Y.; Yan, Z.; Wang, X. Carbon and Phosphorus Characteristics of Different Urban and Rural Organic Waste Composts. Southwest China J. Agric. Sci. 2023, 36, 1455–1464. [Google Scholar]
- Wang, Y.; Li, N.; Zhu, D.; Zhou, W.; Chen, Y.; Wu, Y. Influence of Straw Pretreatment on Phosphorus Forms during the Process of Pig Manure Thermophilic Composting. J. Plant Nutr. Fertil. 2019, 25, 963–971. [Google Scholar] [CrossRef]
- Ge, M.; Zhou, H.; Shen, Y.; Meng, H.; Zhou, J.; Dong, S.; Li, R.; Zhang, X.; Cheng, H.; Wang, J. Effect of Additives on the Succession of Fungal Community in Different Phases of Cattle Manure Composting. China Environ. Sci. 2019, 39, 5173–5181. [Google Scholar]
- Luo, Y.; Liang, J.; Zeng, G.; Chen, M.; Mo, D.; Li, G.; Zhang, D. Seed Germination Test for Toxicity Evaluation of Compost: Its Roles, Problems and Prospects. Waste Manag. 2018, 71, 109–114. [Google Scholar] [CrossRef]
- Yan, X.; Hou, M.; Li, B.; Wang, S.; Liang, Y. Effects of Microbial Inoculant, Biomass Charcoal and Mushroom Residue on Sludge Composting. CAB Rev. Perspect. Agric. Vet. Sci. Nutr. Nat. Resour. 2018, 31, 136–142. [Google Scholar] [CrossRef]
- Luangwilai, T.; Sidhu, H.S.; Nelson, M.I. One-Dimensional Spatial Model for Self-Heating in Compost Piles: Investigating Effects of Moisture and Air Flow. Food Bioprod. Process. 2018, 108, 18–26. [Google Scholar] [CrossRef]
- He, Y.; Inamori, Y.; Mizuochi, M.; Kong, H.; Iwami, N.; Sun, T. Nitrous Oxide Emissions from Aerated Composting of Organic Waste. Environ. Sci. Technol. 2001, 35, 2347–2351. [Google Scholar] [CrossRef]
- Mao, H.; Lv, Z.; Sun, H.; Li, R.; Zhai, B.; Wang, Z.; Awasthi, M.K.; Wang, Q.; Zhou, L. Improvement of Biochar and Bacterial Powder Addition on Gaseous Emission and Bacterial Community in Pig Manure Compost. Bioresour. Technol. 2018, 258, 195–202. [Google Scholar] [CrossRef]
- Sánchez-García, M.; Alburquerque, J.A.; Sánchez-Monedero, M.A.; Roig, A.; Cayuela, M.L. Biochar Accelerates Organic Matter Degradation and Enhances N Mineralisation during Composting of Poultry Manure without a Relevant Impact on Gas Emissions. Bioresour. Technol. 2015, 192, 272–279. [Google Scholar] [CrossRef] [PubMed]
- Seekins, W.; Hutchinson, M.; King, M.; MacDonald, G. Pile Structure in Large Animal Carcass Compost Piles: Zone Differences in Physical and Chemical Characteristics. Compost. Sci. Util. 2015, 23, 67–86. [Google Scholar] [CrossRef]

| Properties | Apparent Density (×103 kg·m−3) | Porosity (%) | SSA (m2·g−1) | Average Pore Size (nm) |
|---|---|---|---|---|
| Biochar | 0.257 ± 0.006 | 60.94 ± 6.62 | 305.52 ± 9.23 | 1.286 ± 0.231 |
| Deer Manure | Straw | Biochar | Zeolite | |
|---|---|---|---|---|
| TOC (g/kg) | 480.88 | 559.07 | 685.01 | - |
| TN (g/kg) | 20.32 | 4.83 | 11.62 | - |
| C/N | 23.66 | 115.84 | 58.95 | - |
| Moisture content (%) | 8.58 | 6.37 | 1.10 | 0.14 |
| Deer Manure (kg) | Straw (kg) | Charcoal (kg) | Zeolite (kg) | Water (kg) | |
|---|---|---|---|---|---|
| CK | 3.05 | 0.95 | 0 | 0 | 5.19 |
| B | 2.98 | 0.54 | 0.48 | 0 | 5.26 |
| Z | 2.69 | 0.83 | 0 | 0.48 | 5.29 |
| BZ | 2.83 | 0.69 | 0.24 | 0.24 | 5.78 |
| TOC | TN | TP | pH | EC | T | GI | MC | |
|---|---|---|---|---|---|---|---|---|
| TN | −0.331 * | |||||||
| TP | −0.458 ** | 0.661 ** | ||||||
| pH | −0.361 * | 0.472 ** | 0.467 ** | |||||
| EC | −0.127 | 0.141 | 0.158 | 0.528 ** | ||||
| T | 0.732 ** | −0.845 ** | −0.675 ** | −0.617 ** | −0.239 | |||
| GI | −0.222 | 0.503 ** | 0.459 ** | 0.102 | −0.097 | −0.355 * | ||
| MC | 0.190 | −0.518 ** | −0.487 ** | −0.143 | 0.058 | 0.446 ** | −0.274 | |
| C/N | 0.709 ** | −0.869 ** | −0.718 ** | −0.587 ** | −0.159 | 0.971 ** | −0.508 ** | 0.458 ** |
| Rotten Evaluation | Water Content [41] | GI Value [29] | C/N [42] | T-value [43] | pH [44] |
|---|---|---|---|---|---|
| Rotten | <40% | >80% | <10 | <0.6 | 8.0–9.0 |
| Relatively rotten | 40–50% | 60–80% | 10–20 | 0.6–0.72 | 7.5–8.0 |
| Not ripe | >50% | <60% | >20 | >0.72 | <7.5 |
| Correlation Coefficient | CK | B | Z | BZ |
|---|---|---|---|---|
| Rotten | 0.8102 | 0.8226 | 0.8316 | 0.8346 |
| Relatively rotten | 0.7824 | 0.7889 | 0.7910 | 0.7792 |
| Not ripe | 0.7677 | 0.7759 | 0.7705 | 0.7542 |
Disclaimer/Publisher’s Note: The statements, opinions and data contained in all publications are solely those of the individual author(s) and contributor(s) and not of MDPI and/or the editor(s). MDPI and/or the editor(s) disclaim responsibility for any injury to people or property resulting from any ideas, methods, instructions or products referred to in the content. |
© 2025 by the authors. Licensee MDPI, Basel, Switzerland. This article is an open access article distributed under the terms and conditions of the Creative Commons Attribution (CC BY) license (https://creativecommons.org/licenses/by/4.0/).
Share and Cite
Xu, J.; Wang, X.; Feng, J.; Zhang, W.; Sun, J. Study of the Relationship Between Nitrogen, Phosphorus Content, and Microbial Community Changes in Deer Manure Compost with Different Conditioners. Fermentation 2025, 11, 66. https://doi.org/10.3390/fermentation11020066
Xu J, Wang X, Feng J, Zhang W, Sun J. Study of the Relationship Between Nitrogen, Phosphorus Content, and Microbial Community Changes in Deer Manure Compost with Different Conditioners. Fermentation. 2025; 11(2):66. https://doi.org/10.3390/fermentation11020066
Chicago/Turabian StyleXu, Jianling, Xinyu Wang, Jiayin Feng, Wenqiu Zhang, and Jitian Sun. 2025. "Study of the Relationship Between Nitrogen, Phosphorus Content, and Microbial Community Changes in Deer Manure Compost with Different Conditioners" Fermentation 11, no. 2: 66. https://doi.org/10.3390/fermentation11020066
APA StyleXu, J., Wang, X., Feng, J., Zhang, W., & Sun, J. (2025). Study of the Relationship Between Nitrogen, Phosphorus Content, and Microbial Community Changes in Deer Manure Compost with Different Conditioners. Fermentation, 11(2), 66. https://doi.org/10.3390/fermentation11020066

